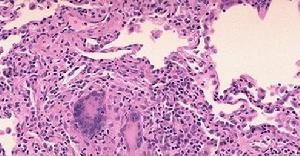
變應性肉芽腫血管炎

疾病概述
 變應性肉芽腫血管炎顯微觀察
變應性肉芽腫血管炎顯微觀察變應性肉芽腫血管炎病因是一變態反應性疾病,Churg-Strauss發現患者有抗鏇毛蟲抗體陽性,但組織中未找到有寄生蟲證據。年來人們發現在大部分患者約75%P-ANCA陽性,推測ANCA在該病的發病中起一定作用,亦有人推測為嗜酸粒細胞釋放陽離子蛋白而損傷血管內皮細胞致病。
症狀體徵
 變應性肉芽腫血管炎影像圖
變應性肉芽腫血管炎影像圖1.前驅期除一般性症狀發熱、全身不適外,常出現多種過敏性疾病的症狀,以呼吸道表現為主,包括變應性鼻炎、鼻息肉病、哮喘和支氣管炎,此期待續數年後進展至血管炎期。
2.血管炎期初起時多伴有全身症狀,如全身不適、消瘦、發熱、腿部肌肉痙攣性疼痛(尤其是腓腸肌)。由於受累血管廣泛分布,此期臨床表現複雜。約2/3病例有皮膚損害,最常見的是皮下小結、瘀斑、紫癜、潰瘍或皮膚血管阻塞。累及心臟時可引起心肌梗死和心力衰竭。周圍神經病變如單神經或多神經炎。腹部器官缺血或梗死所致的腹痛、腹瀉。肺部受累最常見,常有咳嗽,咯血,胸部放射線檢查顯示斑片狀浸潤、結節、瀰漫間質性病變伴有胸液滲出。腎臟損害一般較輕,故通常只有輕微症狀,但也有病情嚴重者表現為鏡下血尿和(或)蛋白尿,可自行消退,也可發生腎功能不全,極少進展至腎衰竭。此期症狀出現後原先的哮喘症狀往往自行緩解。血管炎可急性發作並急劇惡化,以至威脅生命。
3.血管炎後期臨床表現類似於前驅期,通常為嚴重的哮喘,還包括系統性血管炎引起的一系列繼發性改變,如高血壓、心肌梗死、慢性心功能不全、外周神經損傷後遺症等。外周血嗜酸性粒細胞增多在變應性肉芽腫血管炎任何時期均可短暫發作,可反映疾病活動,但也與病情無關。嗜酸性粒細胞浸潤組織通常與外周血嗜酸性粒細胞增多有一定關係,但也不完全如此,主要發生在肺、胃腸道和心臟。偶爾哮喘、嗜酸性粒細胞增多和血管炎可以同時出現。
病理生理
變應性肉芽腫血管炎的發病機制與免疫異常有關。ANCA在間接免疫螢光鏡下可分為2型:p-ANCA和c-ANCA。在變應性肉芽腫血管炎中多為p-ANCA,急性期絕大多數呈陽性,且很快緩解。推測ANCA在該病的發病中起一定作用。亦有人推測為嗜酸性粒細胞釋放陽離子蛋白,該類物質主要侵犯小動脈、小靜脈,被損傷血管形成壞死性肉芽腫,有時類似於假腫瘤,並有淋巴細胞、漿細胞、巨細胞浸潤。受累器官主要有呼吸道、心包及多系統和部位。
診斷檢查
 變應性肉芽腫血管炎的診斷
變應性肉芽腫血管炎的診斷1.支氣管哮喘。
2.白細胞分類中血嗜酸性粒細胞>10%。
3.單發性或多發性單神經病變或多神經病變。
4.遊走性或一過性肺浸潤。
5.鼻竇病變。
6.血管外嗜酸性粒細胞浸潤。
凡具備上述4條或4條以上者可考慮本病的診斷。
實驗室檢查:大部分病人均有血嗜酸性粒細胞增多,為該病的重要特點之一。嗜酸性粒細胞可高達1.5×109/L,甚至高達60×109/L,分類嗜酸性細胞可>50%,部分病人血清IgE顯著升高,並可有IgG增高,且和病情嚴重程度相關。補體多正常,常有貧血,血沉增快,血清抗MPO抗體P-ANCA和(或)c-ANCA可陽性。支氣管肺泡灌洗液中嗜酸粒細胞比例可達33%。尿中可有蛋白和紅細胞,可伴有膿尿或管型。
其他輔助檢查:
1.組織病理學檢查本病主要累及小動脈和小靜脈,冠狀動脈等中等血管也可受侵犯,大血管受累者少見。病變多分布於依次為:肺(肺內浸潤影、哮喘)、皮膚(紫癜、結節)、末梢神經病變、胃腸道、心臟、腎臟、下尿道、關節炎及關節痛。一般常為多器官、多系統受累,腎臟損害較輕,突出表現在肺部。也可僅局限在單個器官或單處組織內,稱之為局限型變應性肉芽腫血管炎,以肺臟和心臟多見。
病理變化多樣,典型的病理改變為嗜酸性粒細胞浸潤、血管外肉芽腫形成及壞死性血管炎,但三者有時並不同時出現,某一病理改變只在病程的某一時期見到。變應性肉芽腫血管炎腎臟的病理特點為腎臟體積通常正常,皮質可見囊腫,偶見梗死灶,由於周圍組織血管壞死和炎細胞浸潤,常造成腎盂和輸尿管增厚,管壁僵硬。
(1)光鏡:
①腎小球:腎小球病變不突出,絕大多數病人腎小球病變輕微,表現為系膜細胞增生或節段性病變,有時可見腎小球節段壞死伴新月體形成。
②血管:50%以上變應性肉芽腫血管炎病人屍檢證實存在血管炎,但經皮腎活檢常受取材影響,標本中血管炎的檢出率相對較低,因而易造成漏診。變應性肉芽腫血管炎病人腎臟中各種大小血管均可受累,從弓狀動脈到進球小動脈,有時還可累及靜脈(最常見葉間靜脈和小靜脈),靜脈受累處常發生肉芽腫樣改變,然而較少侵犯小動脈。血管彈力層常斷裂,腔內血栓形成,動脈可發生瘤樣擴張。變應性肉芽腫血管炎與PAN及韋格納肉芽腫最大的區別為變應性肉芽腫血管炎腎間質中可見大量完整的或變性的嗜酸性粒細胞浸潤。
③腎小管-間質:腎小管改變無特異性,可見變性和再生的小管。間質浸潤明顯,以嗜酸性粒細胞為主,可有少量淋巴細胞、漿細胞和中性白細胞,少數病例可見間質肉芽腫,典型的肉芽腫中心存在由嗜酸性或嗜鹼性物質組成的壞死區,其周見巨噬細胞和較多嗜酸性細胞,變性的嗜酸性細胞和游離的嗜酸性顆粒也較常見,肉芽腫多在鄰小靜脈處。
(2)免疫螢光和(或)電鏡:為非特異性改變,一般電鏡檢查缺乏電子緻密物。
2.超聲心動圖檢查可協助判斷心臟侵犯,最常見的改變為二尖瓣脫垂。
3.肺X線檢查可見短暫性片狀或結節狀肺浸潤,或瀰漫性間質性病變,少數可發現結節灶(往往不形成空洞),約1/3病人有胸腔積液,有時有肺門淋巴結腫大。
鑑別診斷
變應性肉芽腫血管炎炎症病菌
變應性肉芽腫血管炎炎症病菌1.結節性多動脈炎(PAN)過去曾將變應性肉芽腫血管炎歸於PAN中,兩者均為系統性、壞死性血管炎,都有廣泛組織和器官受累,病理表現也有相同之處。但PAN無哮喘及變態反應疾病表現,外周血嗜酸性粒細胞不增多,嗜酸性粒細胞浸潤組織少見,兩者鑑別並不困難。PAN與變應性肉芽腫血管炎受損靶器官也不一致,變應性肉芽腫血管炎常影響外周神經和心臟,雖然腎小球腎炎也較常見,但病情較輕,很少如PAN一樣出現腎衰竭。PAN很少侵犯肺和皮膚,而變應性肉芽腫血管炎常見。另外,PAN經常與B型肝炎病毒感染有關。
2.韋格納肉芽腫儘管韋格納肉芽腫與變應性肉芽腫血管炎靶器官相似,但兩者臨床及病理表現有一定差異,可資鑑別。也有兩者可重疊,此時鑑別困難。韋格納肉芽腫與變應性肉芽腫血管炎均易侵犯呼吸系統,但韋格納肉芽腫往往形成破壞性損害,諸如鼻黏膜形成潰瘍、肺內結節並出現空洞等,變應性肉芽腫血管炎肺受累程度則較韋格納肉芽腫輕,表現為變應性鼻炎、鼻息肉病、肺內一過性浸潤等。兩者X線表現也不相同。變應性肉芽腫血管炎病人皮膚病變常見,達70%,而韋格納肉芽腫僅13%,變應性肉芽腫血管炎易侵犯心臟,韋格納肉芽腫則少見,變應性肉芽腫血管炎病人極少有腎衰竭表現,但韋格納肉芽腫常見,變應性肉芽腫血管炎預後也較韋格納肉芽腫好,對糖皮質激素反應良好,韋格納肉芽腫往往需要加用免疫抑制藥。
3.高嗜酸性粒細胞綜合徵高嗜酸性粒細胞綜合徵與變應性肉芽腫血管炎有許多相同之處,兩者都為系統性疾病,伴有外周血嗜酸性粒細胞增高以及嗜酸性粒細胞浸潤組織,都可表現為Liffler綜合徵、嗜酸性粒細胞性胃腸炎等繼發改變。但高嗜酸性粒細胞綜合徵外周血嗜酸性粒細胞計數要比變應性肉芽腫血管炎高。高嗜酸性粒細胞綜合徵常可伴有瀰漫性中樞神經系統損害、肝脾及全身淋巴結腫大、血栓性栓塞以及血小板減少症,而變應性肉芽腫血管炎少見。高嗜酸性粒細胞綜合徵極少形成血管炎和肉芽腫。兩者對皮質激素反應也不一樣,高嗜酸性粒細胞綜合徵反應較差。
4.慢性嗜酸性粒細胞性肺炎本病女性好發,特點為外周血嗜酸性粒細胞增高,伴肺內持續性浸潤,分布於肺邊緣,與變應性肉芽腫血管炎一過性肺浸潤有明顯區別。慢性嗜酸性粒細胞性肺炎病人也常有特異性體質,部分病人表現為哮喘或變應性鼻炎。本病若反覆發作,組織學變化可與變應性肉芽腫血管炎相似,表現為廣泛的嗜酸性粒細胞浸潤及小血管炎,甚至可見肉芽腫,此時病人往往對糖皮質激素反應良好。
治療方案
 變應性肉芽腫血管炎患者
變應性肉芽腫血管炎患者1.對於病情較輕的病人,可以單用糖皮質激素治療。開始數周,常給予潑尼松40~60mg/d,口服,以後給予小劑量維持至少1年。糖皮質激素的用藥方式、劑量和療程可依據病人具體情況決來定。停藥後應長期隨訪。
2.對重症病人可每天靜脈滴注甲潑尼龍0.5~1.0g,連續使用3~5天后改為口服潑尼松治療。若單用糖皮質激素療效不佳時可加用環磷醯胺、硫唑嘌呤或環孢素衝擊治療。另外,對於急重症病人,血漿置換和血漿吸附治療也可以試用。有用干擾素(300萬U,每周3次皮下使用,共12個月)治療該病成功的個案。也有使用腫瘤壞死因子α的拮抗藥(TNF-alphablockers:etanercept和remicade)成功治療危重複發病例的個案。
3.其他對症治療哮喘可用β腎上腺能興奮藥,但血管炎期禁用。
預後預防
 變應性肉芽腫血管炎預後預防
變應性肉芽腫血管炎預後預防預防:
1.合理套用抗生素及其他藥物預防發生藥物性過敏反應。尤其對高敏體質人群,更應注意避免各種致敏因素。
2.對感染患者,應積極對症治療。對高危人群應及時注射疫苗,以預防引發本病。變應性肉芽腫血管炎在病情控制後部分病人會復發,因此對門診病人的密切隨訪,對復發病例治療的及時和力度是提高預後的必要條件。
常見疾病
| 疾病的存在,是從痛苦和不適等自覺症狀開始的。疾病,有如健康一樣,從不同角度考查可以給出不同的定義。最常套用的定義是"對人體正常形態與功能的偏離。現代醫學對人體的各種生物參數(包括智慧型)都進行了測量,其數值大體上服從統計學中的常態分布規律,即可以計算出一個均值和95%健康個體的所在範圍。 |
